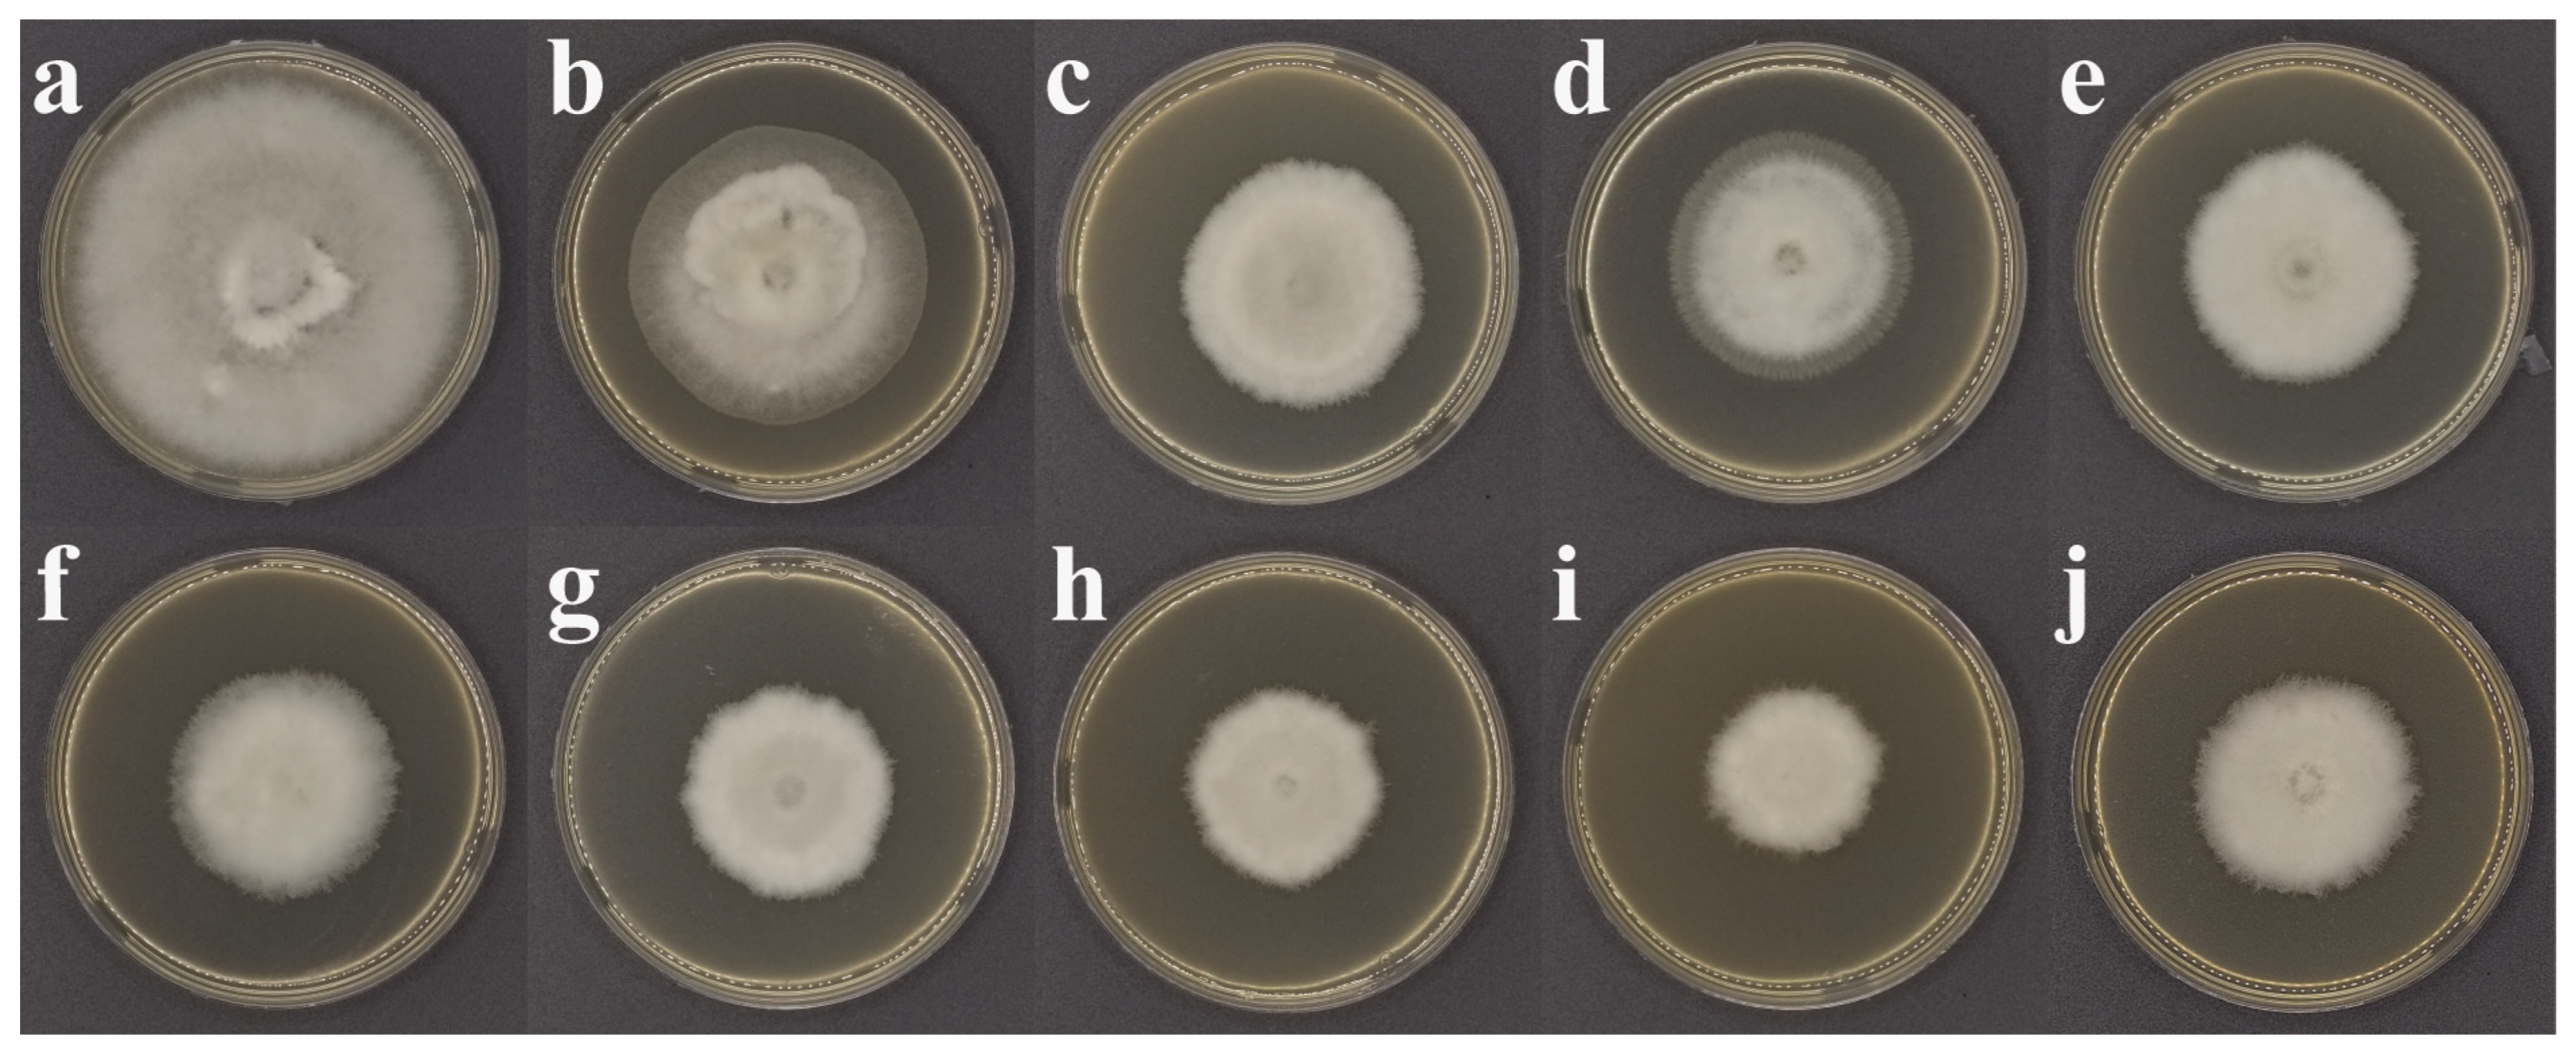
Agronomy 15 00683 g003

Preparation and Synergistic Effect of Composite Solid Nanodispersions for Co-Delivery of Prochloraz and Azoxystrobin
Abstract
1. Introduction
2. Materials and Methods
2.1. Chemicals and Microorganisms
2.2. Preparation of SND Co-Loaded with Prochloraz and Azoxystrobin
2.3. Particle Size and Zeta Potential Measurements
2.4. Morphological Characterization of SND
2.5. Antifungal Activity Assay
2.6. Calculation of Synergistic Coefficient
2.7. Oxidative Stress Assay
2.8. Morphological Characterization of Hyphae
2.9. Cell Membrane Permeability Test
2.10. Contact Angle Measurement
2.11. Surface Tension Measurement
2.12. Cytotoxicity Test
2.13. Statistical Analysis
3. Results
3.1. Characterization of SND Co-Loaded with Prochloraz and Azoxystrobin
3.2. Antifungal Activity of SND
3.3. Fungicidal Mechanism
3.3.1. Effect on Antioxidant Enzyme Activity
3.3.2. Effect on Mycelial Morphology
3.3.3. Effect on Membrane Permeability
3.4. Foliar Wettability
3.5. Cytotoxicity to Non-Target Cells
4. Discussion
5. Conclusions
Supplementary Materials
Author Contributions
Funding
Data Availability Statement
Conflicts of Interest
References
- Newcombe, G.; Harding, A.; Ridout, M.; Busby, P.E. A Hypothetical Bottleneck in the Plant Microbiome. Front Microbiol. 2018, 9, 1645. [Google Scholar] [CrossRef]
- Figueroa, M.; Hammond-Kosack, K.E.; Solomon, P.S. A review of wheat diseases—A field perspective. Mol. Plant Pathol. 2018, 19, 1523–1536. [Google Scholar] [CrossRef]
- Valverde-Bogantes, E.; Bianchini, A.; Herr, J.R.; Rose, D.J.; Wegulo, S.N.; Hallen-Adams, H.E. Recent population changes of Fusarium head blight pathogens: Drivers and implications. Can. J. Plant Pathol. 2020, 42, 315–329. [Google Scholar] [CrossRef]
- Singh, P.K.; Nag, A.; Arya, P.; Kapoor, R.; Singh, A.; Jaswal, R.; Sharma, T.R. Prospects of Understanding the Molecular Biology of Disease Resistance in Rice. Int. J. Mol. Sci. 2018, 19, 1141. [Google Scholar] [CrossRef] [PubMed]
- Franck, W.L.; Gokce, E.; Randall, S.M.; Oh, Y.; Eyre, A.; Muddiman, D.C.; Dean, R.A. Phosphoproteome Analysis Links Protein Phosphorylation to Cellular Remodeling and Metabolic Adaptation during Magnaporthe oryzae Appressorium Development. J. Proteome Res. 2015, 14, 2408–2424. [Google Scholar] [CrossRef]
- Ashfaq, B.; Arshad, H.M.; Atiq, M.; Yousaf, S.; Saleem, K.; Arshad, A. Biochemical Profiling of Resistant Phenotypes Against Bipolaris oryzae Causing Brown Spot Disease in Rice. Front. Agron. 2021, 3, 675895. [Google Scholar] [CrossRef]
- Raveloson, H.; Ramonta, I.R.; Tharreau, D.; Sester, M. Long-term survival of blast pathogen in infected rice residues as major source of primary inoculum in high altitude upland ecology. Plant Pathol. 2018, 67, 610–618. [Google Scholar] [CrossRef]
- Wang, P.; Wu, J.; Zhang, H.; Tang, W.; Chen, Y. Status and evaluation of pesticides for controlling wheat scab in China. Chin. Plant Prot. 2021, 41, 71–76+56. [Google Scholar]
- Feng, J.; Feng, A.; Zhu, X.; Yang, J.; Chen, S.; Su, J. Preventive and Therapeutic Effects of New Fungicides on Rice Blast. Asian Agric. Res. 2023, 15, 33–35. [Google Scholar] [CrossRef]
- Li, B.; Bounpheng, S.; Xuan, Z.; He, Q.; Wu, H. Screening of fungicides on Fusarium wilt of tomato. Chin. Cucurbits Veg. 2021, 34, 61–64. [Google Scholar] [CrossRef]
- Ren, L.; Qin, N.; Ning, J.; Yin, H.; Lü, H.; Zhao, X. Capsicum Endophytic Bacterial Strain LY7 and Prochloraz Synergistically Control Chilli Anthracnose. J. Fungi 2024, 10, 169. [Google Scholar] [CrossRef] [PubMed]
- Ge, C.; Dong, D.; Mao, C.; Zhang, Q.; Zhang, C. Characterization, Molecular Mechanism of Prochloraz-Resistance in Fusarium fujikuroi and Development of Loop-Mediated Isothermal Amplification Rapid Detection Technique Based on the S312T Genotype of Resistances. J. Fungi 2024, 10, 560. [Google Scholar] [CrossRef] [PubMed]
- Shen, G.; Teng, H.; Sun, J.; Xu, X.; Jiao, C.; Fan, X.; Zhou, P.; Wang, X.; Xiang, W.; Zhao, J. Baseline Sensitivity and Toxicity Mechanisms of Prochloraz to Alternaria alternata Strains Associated with Maize Leaf Blight in Heilongjiang Province in China. Plant Dis. 2024, 108, 3336–3344. [Google Scholar] [CrossRef] [PubMed]
- Wei, F.; Su, T.; Wang, D.; Li, H.; You, J. Transcriptomic analysis reveals common pathways and biomarkers associated with oxidative damage caused by mitochondrial toxicants in Chironomus dilutes. Chemosphere 2020, 254, 126746. [Google Scholar] [CrossRef]
- Koleva, M.; Stanoeva, Y.; Ivanova, A.; Chamurliyski, P. Duration of fungicide activity against wheat powdery mildew. Acta Sci. Nat. 2022, 9, 84–92. [Google Scholar] [CrossRef]
- Giorni, P.; Rolla, U.; Romani, M.; Mulazzi, A.; Bertuzzi, T. Efficacy of Azoxystrobin on Mycotoxins and Related Fungi in Italian Paddy Rice. Toxins 2019, 11, 310. [Google Scholar] [CrossRef]
- Saxena, A.; Sarma, B.K.; Singh, H.B. Effect of Azoxystrobin Based Fungicides in Management of Chilli and Tomato Diseases. Proc. Natl. Acad. Sci. India Sect. B Biol. Sci. 2016, 86, 283–289. [Google Scholar] [CrossRef]
- Rhouma, A.; Mehaoua, M.S.; Mougou, I.; Rhouma, H.; Shah, K.K.; Bedjaoui, H. Combining melon varieties with chemical fungicides for integrated powdery mildew control in Tunisia. Eur. J. Plant Pathol. 2023, 165, 189–201. [Google Scholar] [CrossRef]
- Fang, A.; Zhang, R.; Qiao, W.; Peng, T.; Qin, Y.; Wang, J.; Tian, B.; Yu, Y.; Sun, W.; Yang, Y.; et al. Sensitivity Baselines, Resistance Monitoring, and Molecular Mechanisms of the Rice False Smut Pathogen Ustilaginoidea virens to Prochloraz and Azoxystrobin in Four Regions of Southern China. J. Fungi 2023, 9, 832. [Google Scholar] [CrossRef]
- Wang, J.; Chen, S.; Zhou, Y.; Peng, Q.; Shi, N.; Du, Y.; Chen, F. High resistance risk of Phytophthora colocasiae to azoxystrobin in southeastern of China. Pestic. Biochem. Physiol. 2024, 2, 105949. [Google Scholar] [CrossRef]
- Zhao, Z. Use of pesticide mixing and compounding preparations. Northwest Hortic. 2017, 2, 9–10. [Google Scholar]
- Zhu, C.; Ji, Y.; Jiang, H. Analysis of Registration Status of Mixed Pesticide Products in China. Pestic. Sci. Adm. 2015, 36, 20–25+60. [Google Scholar]
- Wang, B. Mix pesticides scientifically and rationally. Hunan Agric. 2021, 11, 19. [Google Scholar]
- Ma, X.; Geng, Z.; Gao, L.; Zhao, J.; Ren, Y.; Li, Q. Toxicity determination of prochloraz, azoxystrobin and their different proportions on Fusarium graminearum. J. Shandong Agric. Univ. 2020, 51, 1044–1048. [Google Scholar] [CrossRef]
- Zuo, G.; Sun, J.; Xia, S. Study on the effect of mixed use of several chemicals on controlling main wheat diseases. Anhui Agric. Sci. Bull. 2019, 25, 90–91+110. [Google Scholar] [CrossRef]
- Gu, C.; Song, Y.; Cong, G. A study on suspension of prochliraz and thifluzamide against rice sheath blight. Jinling Inst. Technol. 2012, 28, 53–55. [Google Scholar] [CrossRef]
- Kah, M.; Beulke, S.; Tiede, K.; Hofmann, T. Nanopesticides: State of Knowledge, Environmental Fate, and Exposure Modeling. Crit. Rev. Environ. Sci. Technol. 2013, 43, 1823–1867. [Google Scholar] [CrossRef]
- Wang, D.; Saleh, N.B.; Byro, A.; Zepp, R.; Sahle-Demessie, E.; Luxton, T.P.; Ho, K.T.; Burgess, R.M.; Flury, M.; White, J.C.; et al. Nano-enabled pesticides for sustainable agriculture and global food security. Nat. Nanotechnol. 2022, 17, 347–360. [Google Scholar] [CrossRef]
- Ma, Y.; Zhang, C.; Du, F. Development tendency and frontiers technology of pesticide formulations. Mod. Agrochem. 2022, 21, 1–8. [Google Scholar] [CrossRef]
- Ding, X.; Gao, F.; Cui, B.; Du, Q.; Zeng, Z.; Zhao, X.; Sun, C.; Wang, Y.; Cui, H. The key factors of solid nanodispersion for promoting the bioactivity of abamectin. Pestic. Biochem. Physiol. 2024, 201, 105897. [Google Scholar] [CrossRef]
- Peng, X.; Lei, C.; Sun, X. Comparison of Lethal Doses Calculated Using Logit/Probit–Log(Dose) Regressions With Arbitrary Slopes Using R. J. Econ. Entomol. 2021, 114, 1345–1352. [Google Scholar] [CrossRef]
- Schmid-Siegert, E.; Stepushenko, O.; Glauser, G.; Farmer, E.E. Membranes as Structural Antioxidants: RECYCLING OF MALONDIALDEHYDE TO ITS SOURCE IN OXIDATION-SENSITIVE CHLOROPLAST FATTY ACIDS. J. Biol. Chem. 2016, 291, 13005–13013. [Google Scholar] [CrossRef]
- Yao, J.; Zhi, H.; Shi, Q.; Zhang, Y.; Feng, J.; Liu, J.; Huang, H.; Xie, X. Tannic acid interfacial modification of prochloraz ethyl cellulose nanoparticles for enhancing the antimicrobial effect and biosafety of fungicides. ACS Appl. Mater. Interfaces 2023, 15, 41324–41336. [Google Scholar] [CrossRef]
- Lundqvist, J.; Hellman, B.; Oskarsson, A. Fungicide prochloraz induces oxidative stress and DNA damage in vitro. Food Chem. Toxicol. 2016, 91, 36–41. [Google Scholar] [CrossRef]
- Vandensande, Y.; Carbone, M.; Mathieu, B.; Gallez, B. Mitochondrial dysfunction induced in human hepatic HepG2 cells exposed to the fungicide kresoxim-methyl and to a mixture kresoxim-methyl/boscalid. Redox Rep. 2024, 29, 2424677. [Google Scholar] [CrossRef]
- Kan, Y.; He, Z.; Keyhani, N.O.; Li, N.; Huang, S.; Zhao, X.; Liu, P.; Zeng, F.; Li, M.; Luo, Z.; et al. A network of transcription factors in complex with a regulating cell cycle cyclin orchestrates fungal oxidative stress responses. BMC Biol. 2024, 22, 81. [Google Scholar] [CrossRef]
- Breitenbach, M.; Weber, M.; Rinnerthaler, M.; Karl, T.; Breitenbach-Koller, L. Oxidative Stress in Fungi: Its Function in Signal Transduction, Interaction with Plant Hosts, and Lignocellulose Degradation. Biomolecules 2015, 5, 318–342. [Google Scholar] [CrossRef]
- Sahu, P.K.; Jayalakshmi, K.; Tilgam, J.; Gupta, A.; Nagaraju, Y.; Kumar, A.; Hamid, S.; Singh, H.V.; Minkina, T.; Rajput, V.D.; et al. ROS generated from biotic stress: Effects on plants and alleviation by endophytic microbes. Front. Plant Sci. 2022, 13, 1042936. [Google Scholar] [CrossRef]
- Tang, J.; Hao, D.; Li, T.; Zhang, H.; Chen, J. Physiological response of Trichoderma asperellum to Na+ stress. Microbiol. China 2021, 48, 23–34. [Google Scholar] [CrossRef]
- Mansuroğlu, B.; Derman, S.; Yaba, A.; Kızılbey, K. Protective effect of chemically modified SOD on lipid peroxidation and antioxidant status in diabetic rats. Int. J. Biol. Macromol. 2015, 72, 79–87. [Google Scholar] [CrossRef]
- Huth, M.A.; Huth, A.; Schreiber, L.; Koch, K. Design of a biomimetic, small-scale artificial leaf surface for the study of environmental interactions. Beilstein J. Nanotechnol. 2022, 13, 944–957. [Google Scholar] [CrossRef] [PubMed]
- Sun, Y.; Gao, X.; Li, J.; Chen, Y. Comparative study on wettability of typical plant leaves and biomimetic preparation of superhydrophobic surface of aluminum alloy. MATEC Web Conf. 2018, 142, 04004. [Google Scholar] [CrossRef]
- Song, Y.; Huang, Q.; Huang, G.; Liu, M.; Cao, L.; Li, F.; Zhao, P.; Cao, C. The effects of adjuvants on the wetting and deposition of insecticide solutions on hydrophobic wheat leaves. Agronomy 2022, 12, 2148. [Google Scholar] [CrossRef]

| Ratio of Prochloraz to Azoxystrobin | Average Particle Size (nm) ± S.D. | PDI ± S.D. |
|---|---|---|
| Single Prochloraz | 10.3 ± 0.02 | 0.252 ± 0.01 |
| Single Azoxystrobin | 14.7 ± 0.31 | 0.092 ± 0.00 |
| 2:1 | 15.2 ± 0.12 | 0.227 ± 0.01 |
| 4:1 | 13.9 ± 0.10 | 0.141 ± 0.05 |
| 5:1 | 13.4 ± 0.05 | 0.021 ± 0.01 |
| 6:1 | 13.4 ± 0.07 | 0.075 ± 0.07 |
| 10:1 | 16.0 ± 0.29 | 0.268 ± 0.01 |
| 14:1 | 13.3 ± 0.04 | 0.020 ± 0.01 |
| Formulation | Toxicity Regression Equation * | Correlation Coefficient | EC50 (mg/L) | 95% Confidence Interval | Synergistic Coefficient |
|---|---|---|---|---|---|
| Prochloraz | Y = 0.5996X + 0.7094 | 0.9818 | 0.066 | 0.043–0.099 | — |
| Azoxystrobin | Y = 0.5716X + 0.3508 | 0.9910 | 0.243 | 0.155–0.428 | — |
| 2:1 SND | Y = 0.8003X + 0.9588 | 0.9975 | 0.067 | 0.046–0.087 | 1.384 |
| 4:1 SND | Y = 0.8382X + 1.1099 | 0.9950 | 0.047 | 0.035–0.064 | 1.644 |
| 5:1 SND | Y = 0.9525X + 1.3835 | 0.9935 | 0.035 | 0.013–0.078 | 2.146 |
| 6:1 SND | Y = 0.9625X + 1.4882 | 0.9945 | 0.028 | 0.012–0.057 | 2.631 |
| 10:1 SND | Y = 0.9392X + 1.6218 | 0.9808 | 0.019 | 0.007–0.038 | 3.720 |
| 14:1 SND | Y = 0.9625X + 1.7836 | 0.9757 | 0.014 | 0.005–0.027 | 4.955 |
| 14:1 ME | Y = 0.8282X + 1.242 | 0.9945 | 0.032 | 0.007–0.089 | 2.168 |
| Formulation | Toxicity Regression Equation * | Correlation Coefficient | EC50 (mg/L) | 95% Confidence Interval | Synergistic Coefficient |
|---|---|---|---|---|---|
| Prochloraz | Y = 0.7788X + 0.9461 | 0.9955 | 0.061 | 0.044–0.084 | — |
| Azoxystrobin | Y = 0.5611X + 0.0928 | 0.9706 | 0.683 | 0.391–1.524 | — |
| 2:1 SND | Y = 0.7082X + 0.7540 | 0.9854 | 0.058 | 0.040–0.082 | 1.510 |
| 4:1 SND | Y = 0.7069X + 0.9508 | 0.9925 | 0.045 | 0.031–0.064 | 1.657 |
| 5:1 SND | Y = 0.6895X + 0.9734 | 0.9920 | 0.039 | 0.026–0.055 | 1.844 |
| 6:1 SND | Y = 0.6362X + 0.9113 | 0.9793 | 0.037 | 0.024–0.054 | 1.895 |
| 10:1 SND | Y = 0.6305X + 0.9312 | 0.9772 | 0.033 | 0.021–0.049 | 2.015 |
| 14:1 SND | Y = 0.6808X + 1.1168 | 0.9925 | 0.023 | 0.015–0.033 | 2.824 |
| 14:1 ME | Y = 0.7029X+ 1.0142 | 0.9884 | 0.036 | 0.024–0.051 | 1.804 |
Disclaimer/Publisher’s Note: The statements, opinions and data contained in all publications are solely those of the individual author(s) and contributor(s) and not of MDPI and/or the editor(s). MDPI and/or the editor(s) disclaim responsibility for any injury to people or property resulting from any ideas, methods, instructions or products referred to in the content. |
© 2025 by the authors. Licensee MDPI, Basel, Switzerland. This article is an open access article distributed under the terms and conditions of the Creative Commons Attribution (CC BY) license (https://creativecommons.org/licenses/by/4.0/).
Share and Cite
Wang, T.; Chen, F.; Ding, X.; Gao, F.; Du, Q.; Zeng, Z.; Cui, H.; Cui, B. Preparation and Synergistic Effect of Composite Solid Nanodispersions for Co-Delivery of Prochloraz and Azoxystrobin. Agronomy 2025, 15, 683. https://doi.org/10.3390/agronomy15030683
Wang T, Chen F, Ding X, Gao F, Du Q, Zeng Z, Cui H, Cui B. Preparation and Synergistic Effect of Composite Solid Nanodispersions for Co-Delivery of Prochloraz and Azoxystrobin. Agronomy. 2025; 15(3):683. https://doi.org/10.3390/agronomy15030683
Chicago/Turabian StyleWang, Tingyu, Fangyuan Chen, Xiquan Ding, Fei Gao, Qian Du, Zhanghua Zeng, Haixin Cui, and Bo Cui. 2025. "Preparation and Synergistic Effect of Composite Solid Nanodispersions for Co-Delivery of Prochloraz and Azoxystrobin" Agronomy 15, no. 3: 683. https://doi.org/10.3390/agronomy15030683
APA StyleWang, T., Chen, F., Ding, X., Gao, F., Du, Q., Zeng, Z., Cui, H., & Cui, B. (2025). Preparation and Synergistic Effect of Composite Solid Nanodispersions for Co-Delivery of Prochloraz and Azoxystrobin. Agronomy, 15(3), 683. https://doi.org/10.3390/agronomy15030683








